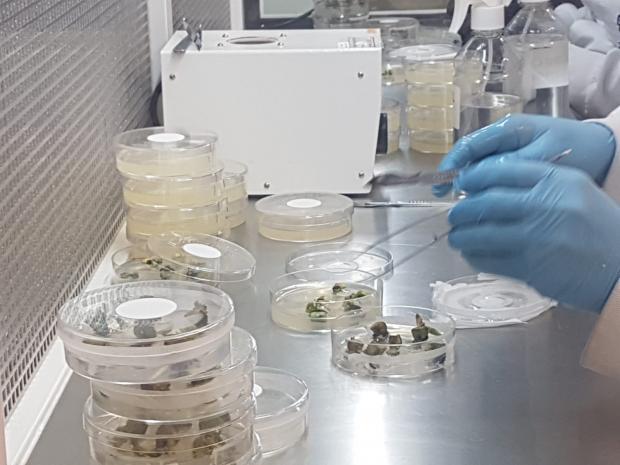
service-img3

Nova gestão do COPASEM assume com foco no fortalecimento da sanidade de sementes no Brasil
A nova gestão do Comitê de Patologia de Sementes (COPASEM), vinculado à Associação Brasileira de Tecnologia de Sementes (ABRATES), inicia seus trabalhos com uma missão clara: fortalecer a sanidade das sementes produzidas no Brasil. Diante de desafios técnicos, estruturais e regulatórios, o comitê aposta na capacitação profissional, na padronização de metodologias e na integração dos diferentes elos do setor.
À frente do comitê estão a coordenadora Norimar D´Ávila Denardin, sócia-diretora e pesquisadora do Centro de Biotecnologia na Agricultura (CEBTECAGRO), e a vice-coordenadora Carla Corrêa, CEO da CLC AgroCapacitação. Com foco em inovação e articulação técnica, elas conduzirão ações estratégicas que visam à produção de sementes mais sadias e seguras, essenciais para conceder caráter de sustentabilidade à agricultura nacional.
"Precisamos garantir qualidade desde o laboratório até o campo", afirma Norimar Denardin.
Segundo ela, uma das prioridades da nova gestão é criar uma rede de padronização e validação de análises fitopatológicas, envolvendo universidades e instituições de pesquisa públicas e privadas.
Entre os principais gargalos do setor estão a escassez de profissionais especializados, a limitação de recursos em infraestrutura e a falta de metodologias diagnósticas padronizadas. Norimar ressalta ainda que há um grande déficit de laboratórios bem equipados e de pessoal capacitado para operar tecnologias modernas e interpretar resultados complexos, especialmente em regiões afastadas dos grandes centros.
Ela destaca que técnicas avançadas – como as baseadas em biologia molecular, a exemplo da PCR (Reação em Cadeia da Polimerase), eletroforese, sequenciamento de DNA, hibridização, técnicas isotérmicas, como o Lamp (Loop-mediated isothermal amplification) e ELISA – demandam investimentos significativos em equipamentos, reagentes e infraestrutura, o que dificulta sua adoção em larga escala nacional.
Além disso, há escassez de técnicos aptos a operar essas tecnologias e interpretar os resultados com precisão. Esse déficit limita a realização de análises complexas e compromete a resposta à diversidade de patógenos, presente no País. "A diversidade de patógenos exige metodologias sensíveis, rápidas e precisas. No entanto, sua implementação tem enfrentado barreiras técnicas e financeiras, além de capacitação contínua das equipes ativas", enfatiza.
A vice-coordenadora Carla Corrêa também ressalta a importância de superar resistências à adoção de novas metodologias: "Vamos atuar em parceria com agências de fomento e instituições públicas e privadas para garantir acesso à tecnologia, formação profissional e difusão do conhecimento", afirma.
No campo prático, o COPASEM pretende apoiar estratégias integradas de controle de patógenos, promovendo o uso adequado de tratamentos químicos, biológicos e físicos, além de incentivar o desenvolvimento de agentes de biocontrole mais eficazes e seguros. Segundo as coordenadoras, essas soluções exigem maior investimento em pesquisa e capacitação técnica por parte dos usuários finais.
Atualmente, o Brasil conta com laboratórios oficiais, como os do LANAGRO, do Ministério da Agricultura e Pecuária, e o Instituto Biológico de São Paulo, além de aproximadamente 190 laboratórios credenciados pelo MAPA até setembro de 2023. "No entanto, nem todos estão ativos ou habilitados para o diagnóstico fitossanitário. Há também laboratórios vinculados a universidades e instituições de pesquisa públicas e privadas, mas o número total ainda é impreciso", observa Carla.
"A situação evidencia a urgência de incentivos para manutenção e expansão desses serviços essenciais", reforça Norimar Denardin.
O comitê pretende intensificar o diálogo com órgãos reguladores e entidades representativas, como a Associação Brasileira de Sementes e Mudas (ABRASEM) e as associações estaduais. A estratégia contempla ainda a ampliação da oferta de cursos, workshops e simpósios, além de incentivar a publicação de artigos científicos em periódicos como o Journal of Seed Science e o Informativo ABRATES. "Nosso objetivo é atualizar e disseminar o conhecimento técnico-científico em patologia de sementes, além de conectar o Brasil a experiências internacionais que possam nos fortalecer", afirma Carla.
A grande meta da nova gestão é consolidar o COPASEM como referência nacional e internacional em sanidade de sementes.
"Superar esses desafios exige um esforço colaborativo entre instituições de pesquisa, órgãos governamentais, setor produtivo e os laboratórios, com investimentos em pesquisa, infraestrutura, capacitação e políticas públicas voltadas à área. O impacto será direto na produtividade agrícola, na segurança alimentar e na competitividade do Brasil no mercado global", conclui Norimar Denardin.
COPASEM e os Desafios da Sanidade de Sementes no Brasil
1. Desafios Gerais e Metas do COPASEM
Entre os principais desafios, destacam-se:
- Escassez de profissionais especializados e laboratórios capacitados.
- Deficiência na padronização e validação de metodologias de análise.
- Dificuldade na atualização e disseminação de conhecimento técnico.
- Necessidade de articulação entre universidades, empresas, órgãos de fiscalização e pesquisa.
- Diversidade regional das culturas e fitossanidade.
- Adoção e integração de novas tecnologias.
- Busca por financiamento e maior visibilidade institucional.
As metas gerais envolvem:
- Elevação dos padrões sanitários.
- Formação e capacitação contínua de profissionais.
- Fortalecimento da rede de laboratórios.
- Produção e divulgação de informações técnicas confiáveis.
- Promoção de eventos e debates técnicos.
- Apoio à pesquisa e inovação.
- Colaboração com entidades do agronegócio e organismos internacionais.
2. Diagnóstico: Desafios Técnicos e Estruturais nos Laboratórios
Os laboratórios enfrentam entraves como:
- Complexidade e diversidade dos patógenos.
- Falta de protocolos padronizados e métodos mais sensíveis.
- Dificuldade de detectar patógenos em final de ciclo.
- Interferência de microrganismos saprófitas.
- Infraestrutura limitada e altos custos operacionais.
- Falta de profissionais treinados em técnicas moleculares e interpretação de dados.
- Resistência à adoção de novas metodologias.
- Necessidade de capacitação contínua e maior integração entre pesquisa e aplicação prática.
3. Manejo Fitossanitário: Obstáculos e Necessidades
No campo, os principais desafios do manejo incluem:
- Adoção de estratégias preventivas com base em diagnóstico preciso.
- Escolha eficaz do tratamento de sementes (químico, biológico ou físico).
- Desenvolvimento e validação de métodos de biocontrole.
- Integração de diferentes técnicas de manejo.
- Atualização e capacitação de técnicos e produtores.
- Acesso às informações atualizadas e regulamentações claras.
4. Formação Profissional: Um Gargalo Urgente
Há um déficit crítico de especialistas em patologia de sementes, marcado por:
- Pouca formação específica e aprofundada.
- Desconexão entre a academia e o setor produtivo.
- Envelhecimento da mão de obra e pouca renovação.
- Baixa visibilidade e incentivo à área.
- Falta de disciplinas específicas nas universidades.
- Necessidade de formação continuada e valorização dos profissionais.
5. Atualização dos Conteúdos e Metodologias
Os cursos enfrentam barreiras como:
- Rápido avanço tecnológico e científico.
- Emergência constante de novos patógenos.
- Alto custo das tecnologias e infraestrutura.
- Falta de especialistas e materiais atualizados.
- Metodologias de ensino defasadas e pouca integração teoria-prática.
- Baixa difusão do conhecimento fora do meio acadêmico.
6. Estrutura dos Laboratórios no Brasil
O cenário atual é composto por:
- Laboratórios oficiais: como os do LANAGRO (MAPA) e Instituto Biológico de SP.
- Laboratórios credenciados pelo MAPA (RENASEM): cerca de 190 até setembro de 2023.
- Laboratórios não oficiais e não credenciados: de universidades, Embrapa e empresas, com número exato desconhecido.
7. Prioridades do COPASEM
- Formação profissional como pilar para suprir a escassez de especialistas.
- Pesquisa aplicada, voltada a novas metodologias e manejo sustentável.
- Investimento em tecnologia, modernizando estruturas laboratoriais.
- Difusão eficaz do conhecimento, tornando-o acessível a técnicos, produtores e usuários finais.
